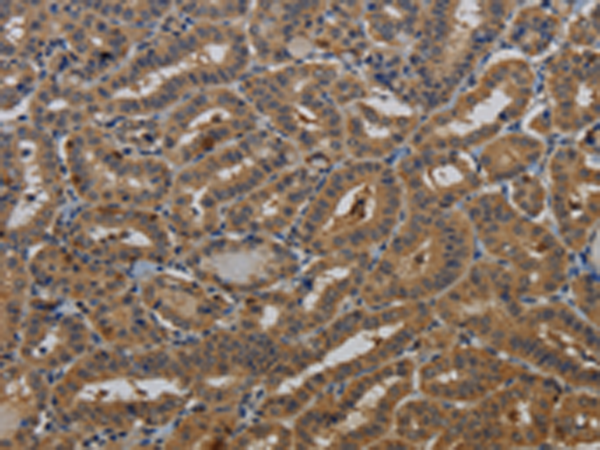
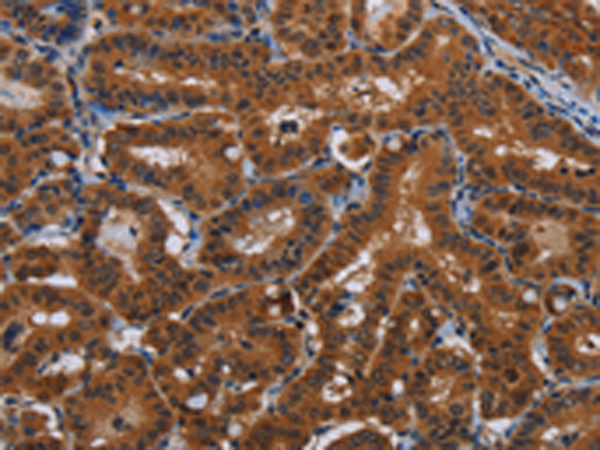
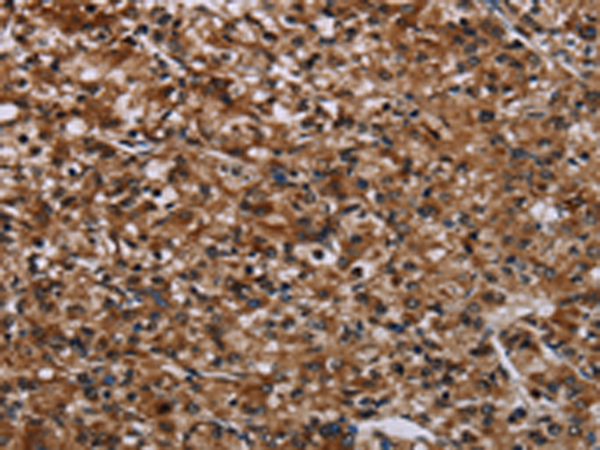

-
分类: 科研抗体货号: P08460别名: Kv7.5应用: WB,IHC反应种属: Human, Mouse
-
分类: 科研抗体货号: P08461别名: SAX2; LTXS1; SATX2; SPAX2; SPG58应用: WB,IHC反应种属: Human, Mouse, Rat
-
分类: 科研抗体货号: P08479别名: IN; LHR; MC56; MDU2; MDU3; MIC4; Pgp1; CDW44; CSPG8; HCELL; HUTCH-I; ECMR-III应用: WB反应种属: Human
-
分类: 科研抗体货号: P08459别名: LQT; RWS; WRS; LQT1; SQT2; ATFB1; ATFB3; JLNS1; KCNA8; KCNA9; Kv1.9; Kv7.1; KVLQT1应用: WB,IHC反应种属: Human, Mouse, Rat
-
分类: 科研抗体货号: P08478别名: 90K; M2BP; gp90; CyCAP; BTBD17B; MAC-2-BP; TANGO10B应用: IHC反应种属: Human
-
分类: 科研抗体货号: P08457别名: TALK2; TASK4; TALK-2; TASK-4; K2p17.1应用: WB,IHC反应种属: Human
-
分类: 科研抗体货号: P08477别名: CAR; LEU5; RFP2; DLEU5; RNF77应用: IHC反应种属: Human, Mouse, Rat
-
分类: 科研抗体货号: P08454别名:应用: IHC反应种属: Human, Mouse
-
分类: 科研抗体货号: P08476别名: OB; OBS; LEPD应用: IHC反应种属: Human, Mouse, Rat
-
分类: 科研抗体货号: P08452别名: 5qNCA; NET22; C5orf7; JMJD1B应用: IHC反应种属: Human, Mouse

鄂公网安备42018502007531号
鄂公网安备42018502007531号

